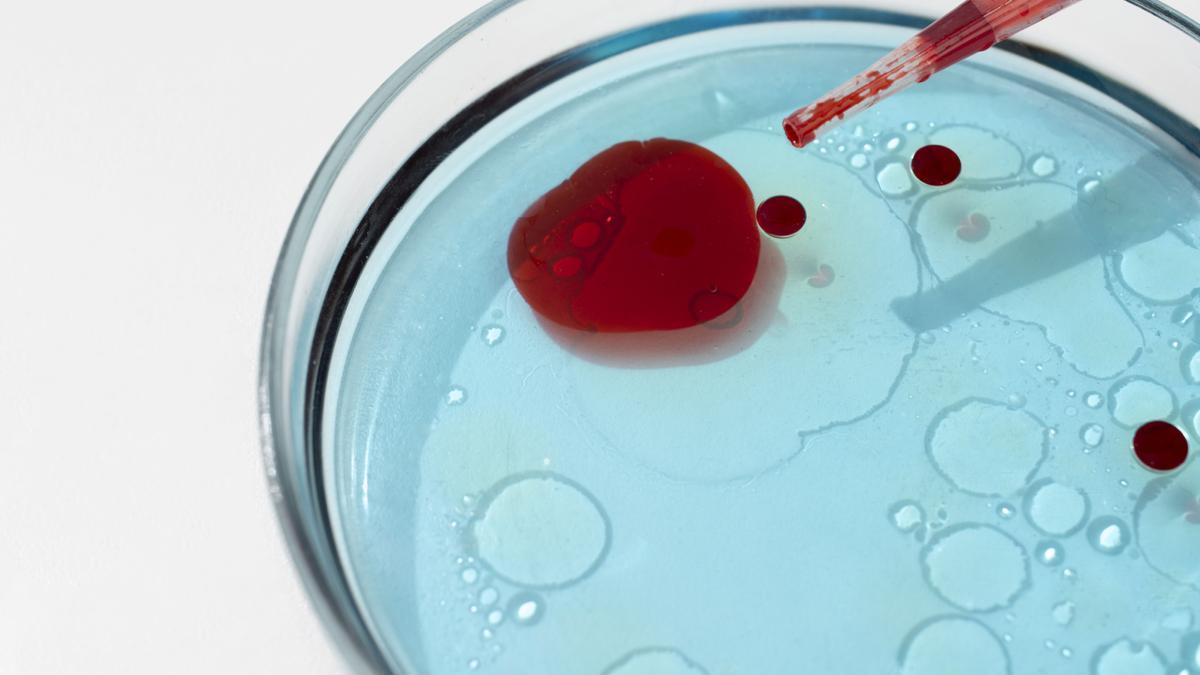
El cansancio, la palidez o la dificultad para concentrarse son algunos de los síntomas habituales.

La Sociedad Española de Hematología y Hemoterapia (SEHH) recuerda la importancia de visibilizar una enfermedad muy prevalente, pero a menudo infradiagnosticada, que afecta de manera significativa a la calidad de vida de millones de personas en todo el mundo.
La anemia es un problema de salud pública global, especialmente frecuente en niños pequeños, mujeres en edad fértil, embarazadas y personas mayores. Se estima que hasta el 40% de los niños de entre 6 meses y 4 años, el 37% de las mujeres embarazadas, y el 30% de las mujeres de 15 a 49 años presentan anemia a escala mundial, siendo la deficiencia de hierro (anemia ferropénica) su causa más común.
No obstante, esta enfermedad también afecta a los varones, con una frecuencia que oscila entre el 5-6% en gente joven, y el 50% en mayores de 80 años. “La anemia no es solo una cifra baja en una analítica; es la manifestación de que algo no está funcionando correctamente en el organismo y siempre debe investigarse su causa”, explica Marta Morado, hematóloga experta en Eritropatología y directora médica de la SEHH.
Desde la SEHH se subraya que el hematólogo es el especialista de referencia para el diagnóstico, tratamiento y seguimiento de la anemia. “Más allá de corregir el descenso de la hemoglobina, el abordaje especializado permite identificar el origen del problema, que en nuestro entorno se debe con frecuencia a sangrados crónicos, problemas de absorción o aumentos de las necesidades de hierro, como ocurre durante el embarazo o el crecimiento”, señala.

No hay que normalizar el cansancio y acudir al médico ante síntomas persistentes.
El diagnóstico
“La anemia ferropénica es un proceso progresivo. Primero se agotan los depósitos de hierro y, si no se corrige la causa, acaba apareciendo la anemia. Detectarla a tiempo evita complicaciones y mejora claramente la calidad de vida del paciente”, añade la doctora Morado.
Aunque la anemia ferropénica es la más frecuente en el mundo, hay muchas otras causas de anemia, no relacionadas con el déficit de hierro, y que se pueden deber a estados inflamatorios, enfermedades autoinmunes, enfermedades neoplásicas, insuficiencias medulares o alteraciones congénitas en la formación de los eritrocitos.
El cansancio persistente, la debilidad, la palidez o la dificultad para concentrarse son algunos de los síntomas más habituales, aunque no siempre se reconocen como señales de alerta. La anemia es, además, una de las principales causas de absentismo laboral y de limitación funcional, especialmente en mujeres.
Por ello, la SEHH insiste en “la necesidad de no normalizar el cansancio, acudir al médico ante síntomas persistentes y realizar un diagnóstico adecuado, que incluya la valoración de los depósitos de hierro y un estudio de la causa subyacente”.